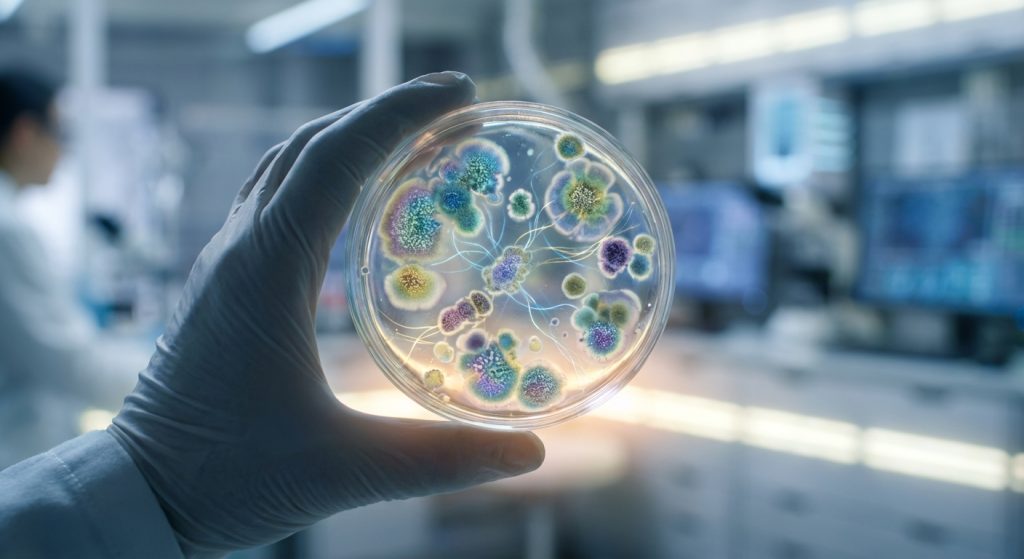

Personalized Probiotics: Sequence Your Gut First
Published on February 6, 2026 by Admin

The world of probiotics is booming. Many people seek them for better gut health. However, not all probiotics are created equal. Furthermore, they don’t work the same for everyone. This is because our gut microbiomes are unique. Therefore, a one-size-fits-all approach often fails. Personalized probiotics are the future. They start with understanding your specific gut. This means sequencing your microbiome. This article explores why this is crucial for effective supplementation.
Why Your Gut Microbiome Matters
Your gut microbiome is a complex ecosystem. It contains trillions of microorganisms. These include bacteria, fungi, and viruses. They live primarily in your large intestine. This ecosystem plays a vital role. It affects digestion. It also impacts immunity. Moreover, it influences mental health. The gut-brain axis is a key connection. It shows how gut health affects mood and cognition. Therefore, maintaining a balanced microbiome is essential.
The Imbalance: Dysbiosis
An imbalance in gut bacteria is called dysbiosis. This can happen for many reasons. Antibiotics are a common culprit. Poor diet is another major factor. Stress also plays a significant role. Furthermore, genetics can influence your gut. Dysbiosis can lead to various health issues. These include irritable bowel syndrome (IBS). It can also contribute to inflammatory bowel disease (IBD). Other issues include allergies and obesity. Some research even links it to autoimmune diseases and mood disorders.
The Limitations of Generic Probiotics
Generic probiotics offer a broad spectrum of bacteria. They often contain strains like Lactobacillus and Bifidobacterium. While beneficial for some, they may not address your specific needs. For example, someone with a deficiency in a particular bacterial species might not benefit from a supplement that doesn’t contain it. In essence, you might be taking something that doesn’t target your unique gut challenges.
Moreover, some strains might even be counterproductive. They could exacerbate existing imbalances. This is why a generic approach can lead to disappointment. You might spend money and time with little to no improvement. Sometimes, symptoms can even worsen.
The Power of Gut Sequencing
Gut sequencing, also known as microbiome analysis, offers a solution. It provides a detailed map of your gut’s microbial landscape. This process involves collecting a stool sample. This sample is then analyzed in a lab. Advanced technology identifies the types and quantities of microbes present. It also reveals their functional potential. This means understanding what these microbes are doing.
What Does Sequencing Tell You?
Sequencing provides valuable insights. It highlights:
- Dominant bacterial species.
- Presence of beneficial microbes.
- Abundance of potentially harmful microbes.
- Diversity of the microbiome.
- Metabolic pathways active in your gut.
This data is more than just a list of bacteria. It’s a personalized health report. It tells you what your gut needs. It also reveals what might be causing problems.
Personalized Probiotic Formulation
Armed with sequencing data, probiotic selection becomes precise. Instead of guessing, you can choose specific strains. These strains are selected to:
- Replenish missing beneficial bacteria.
- Crowd out harmful or opportunistic bacteria.
- Support specific metabolic functions.
- Address identified deficiencies.
This tailored approach significantly increases the chances of success. It moves beyond general well-being to targeted therapeutic outcomes. For instance, if your sequencing reveals a lack of Akkermansia muciniphila, a probiotic rich in this specific strain can be recommended. This bacterium is known for its role in gut barrier integrity and metabolic health.
Beyond Probiotics: Prebiotics and Diet
Personalized recommendations often extend beyond probiotics. They may include specific prebiotics. Prebiotics are fibers that feed beneficial gut bacteria. Therefore, choosing the right prebiotics is also crucial. For example, fructans might be recommended if certain short-chain fatty acid producers are low. Dietary changes are also key. Understanding your gut’s needs can inform your food choices. This creates a holistic approach to gut health. You can learn more about how diet influences your body in articles discussing personalized DNA-driven nutrition.
How to Get Started
The journey to personalized probiotics begins with a consultation. A gastroenterologist or a functional medicine practitioner can guide you. They will explain the process. They will also help interpret the results. Many companies now offer direct-to-consumer microbiome testing kits. However, professional interpretation is often recommended. This ensures you get the most accurate and actionable advice.
What to Expect from Testing
Typically, you will receive a kit. You collect a stool sample at home. You then mail it back to the lab. Results usually take a few weeks. Your practitioner will then discuss the findings. They will help you choose the right supplements and dietary changes. This partnership is vital. It ensures you use the data effectively. For example, understanding your gut’s resilience might also inform other health choices, such as those related to holistic stress management.
The Future of Gut Health
Personalized probiotics are just the beginning. As our understanding of the microbiome grows, so will the possibilities. We will see more sophisticated diagnostics. We will also see more targeted interventions. This includes precision prebiotics, postbiotics, and even personalized phage therapies. The goal is to optimize gut health for everyone. This will lead to better overall well-being. It can also help prevent chronic diseases.
Challenges and Considerations
While promising, personalized probiotics are not without challenges. The technology is still evolving. Costs can be a barrier for some. Also, regulatory oversight is still developing. It is important to work with reputable providers. Always consult with a healthcare professional. They can ensure the recommendations are safe and appropriate for your individual health status.
Frequently Asked Questions
What is gut sequencing?
Gut sequencing, or microbiome analysis, is a laboratory test that identifies the types and amounts of microorganisms in your gut. It provides a detailed profile of your unique gut ecosystem.
Can I take probiotics without sequencing my gut?
Yes, you can. However, generic probiotics may not be effective for everyone. Sequencing allows for a targeted, personalized approach, increasing the likelihood of positive results.
How long does it take to see results from personalized probiotics?
Results can vary. Some individuals notice improvements within weeks. Others may take several months. Consistency and adherence to dietary recommendations are key.
Are personalized probiotics expensive?
The cost can vary. Microbiome testing kits and personalized supplements can be more expensive than generic options. However, the potential for better health outcomes may justify the investment for some.
Can personalized probiotics cure diseases?
Personalized probiotics are not a cure for diseases. However, they can be a powerful tool in managing symptoms and improving overall gut health. They are often part of a broader treatment plan recommended by a healthcare professional.
Conclusion
In conclusion, the era of generic supplements is giving way to a more precise approach. Personalized probiotics, informed by gut sequencing, offer a powerful way to optimize your health. By understanding your unique microbiome, you can make informed choices. These choices lead to more effective interventions. Therefore, sequencing your gut before you supplement is a smart step. It paves the way for a healthier, more balanced you. This personalized approach aligns with the broader trend towards AI in personalized healthcare, aiming for tailored solutions for individual needs.

